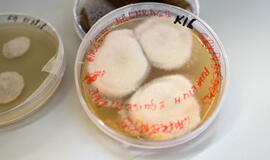

Klaipėdos universiteto mokslininkės dr. Tatjana Paulauskienė ir dr. Marija Kataržytė sukūrė technologiją, kai, panaudojant šiaudus ir Baltijos jūros pakrantėje randamus mikroorganizmus – grybus, galima greitai suskaidyti ir surinkti vandenyje išsiliejusius naftos produktus.
Efektyviausi – šiaudai
Mokslininkės kartu su projekto „InoBioTech Baltija“ komanda pastaruosius mėnesius laboratorijos sąlygomis testavo įvairias iš vandens ir smėlio išskirtas mikroorganizmų kultūras bei skirtingus natūralios kilmės sorbentus: kankorėžius, samanas, dumblius, šuns plaukus, vilną, medienos drožles ir šiaudus.
Iš visų bandytų sorbentų geriausias rezultatas gautas naudojant šiaudus.
Mokslininkai šiaudus hidrofobizavo, kad jie netrauktų vandens, tik surinktų naftos teršalus ir kuo ilgiau išsilaikytų vandens paviršiuje.
Kitame etape ant šiaudų perkeltos ir auginamos tam tikrų mikroorganizmų rūšys - bakterijos ir grybai.
„Ėmėme mėginius iš nuosėdų, tai buvo atlikta su aplinkosaugininkų pagalba. Laboratorijoje naudodami naftą kaip maisto šaltinį mikroorganizmams, pagausiname tuos mikroorganizmus, kurie turi potencialą skaidyti naftos produktus.
Pasirinktus mikroorganizmus, šiuo atveu grybus, auginame kultūroje ir į tą kultūrą įdedame sorbentus, kuriuos tie grybai apauga. Kitaip tariant, jie imobilizuojasi – mikroorganizmai prisitvirtina prie substrato.
Tada sorbentą galime naudoti kaip kompleksą, kuriame yra medžiaga, susiurbianti naftą, ir mikroorganizmai, kurie gali skaidyti naftą“, - procesą nupasakojo Jūros tyrimų instituto mokslininkė M. Kataržytė.
Viena iš biotechnologijos kūrėjų T. Paulauskienė pabrėžė, kad labai svarbu, jog išsklaidžius sorbentus ant naftos dėmės jie kuo ilgiau išsilaikytų vandens paviršiuje, spėtų absorbuoti naftos taršą ir plūduriuotų vandens paviršiuje, kol bus surinkti ir perkelti į specialias naftos utilizavimui skirtas vietas.
Taip pat, pasak mokslininkės, svarbi užduotis buvo sukurti produktą, kuris surinktų naftos produktus, bet ne vandenį.
„Laboratorijoje gauti rezultatai džiugina: pasirinktų mikroorganizmų imobilizavimas nemažina sorbentų plūdrumo bei sėkmingai leidžia surinkti naftos taršą laboratorinėmis sąlygomis“,- pasakojo mokslininkė.
Surenka akimirksniu
Mokslininkų komanda laboratorijoje pademonstravo, kaip veikia jų sukurtas inovatyvus produktas.
Į indą su vandeniu įlašinus naftos, ant paviršiaus susidarė jos plėvelė. Tuomet tiesiai ant naftos plėvelės buvo uždėta sorbento su mikroorganizmais ir nafta akimirksniu buvo pradėta absorbuoti.
„Vienas gramas medžiagos gali sugerti maždaug 10 kartų daugiau naftos produktų.
Projekto metu norime paruošti tris kilogramus medžiagos, kurią norėtume testuoti realiomis sąlygomis. Toks kiekis medžiagos galėtų sugerti apie 30 litrų naftos teršalų. Tai yra tikrai nemažai, nes plėvelė ant vandens paviršiaus būna labai plona, mažiau nei 1 milimetras“, - pasakojo T. Paulauskienė.
Sorbentui sugėrus naftos produktus, jie tarsi užblokuojami ir negali patekti atgal į vandenį. Tuomet darbą pradeda mikroorganizmai, kurie skaido teršalus.
Kadangi technologijoje naudojami mikroorganizmai nefunkcionuoja esant šaltu oru, šis produktas geriausiai būtų pritaikomas pavasarį, vasarą ir rudenį, kai temperatūra nėra žemesnė nei 15 laipsnių.
Tačiau sugerti teršalus sorbentas gali įvairioje aplinkoje.
„Temperatūra svarbi mikroorganizmams, kurių aktyvumas didėja orui šylant. Optimaliausia naudojimo temperatūra būtų nuo 15-20 laipsnių, tada naftos skaidymo procesas ypač suaktyvėja“, - pasakojo M. Kataržytė.
Atgal neišsiskiria
Mokslininkai savo sukurtą technologiją išbandė su žaliavine nafta, jūriniu dyzelinu ir tepalais, kadangi tai yra pagrindiniai produktai, kurie gali išsilieti Baltijos jūroje.
„Svarbu juos kuo greičiau surinkti, nes yra paskaičiuota, kad per pirmąją parą išgaruoja apie 30 procentų naftos. Išgaruoja lakūs, pavojingi kancerogeniniai elementai. Todėl staigus jų surinkimas, blokavimas ir skaidymo pradžia – kuo greičiau, tuo geriau.
Dėl to uoste įvykus išsiliejimui, formuojamos boninės užtvaros, kad teršalai neplistų, būtų vienoje vietoje ir būtų lengviau surinkti. Mūsų sukurtą medžiagą būtų galima tam naudoti, tik reikia sugalvoti tam tikrą dizainą, kaip ją lengviau išbarstyti ant teršalų dėmės, o vėliau – surinkti iš vandens“, - pasakojo T. Paulauskienė.
Taip pat stebima, ar naftos produktai, juos surinkus, vėl neišsiskiria į aplinką, tačiau, T. Paulauskienės teigimu, per dvi savaites trukusius stebėjimus to neužfiksuota.
„Jei naudojama medžiaga būtų nemodifikuota, be mikroorganizmų, po tam tikro laiko vyksta desorbcija. Mūsų atveju matome nuolat mažėjantį naftos kiekį, vadinasi, mūsų mikroorganizmai atlieka savo darbą. Nematome desorbcijos nei vandenyje, nei sorbente“, - patikino T. Paulauskienė.
Svarstoma, kad šiaudai su mikroorganizmais galėtų būtų panaudoti boninėse užtvarose, įdedant produktą į jų vidų, arba „supakuoti“ į iš dumblių pagamintą irią ir aplinkai draugišką plėvelę.
Iki šiol nebandyta technologija
Mokslininkių teigimu, naftos teršalų valymui vandenyje dažniausiai naudojami mechaniniai, cheminiai ar biologiniai metodai, turintys ir tam tikrų pranašumų, ir trūkumų.
Neretas iš jų sukuria kitą problemą – antrinę taršą.
Dėl to norint panaudoti dispergentus, chemines medžiagas, kurios skaldo naftos produktus, reikia gauti aplinkosaugininkų leidimą.
Klaipėdos universiteto Jūros valymo laboratorijoje kuriamas biologinis naftos teršalų valymo metodas bus ir draugiškas aplinkai, ir turės gerą naftos skaidymo potencialą.
Klaipėdos mokslininkų kūrinio išskirtinumas yra ir tai, kad naftos produktams skaidyti pritaikyti grybai.
Iki šiol, turimais duomenimis, panašiai buvo naudojamos tik bakterijos.
Dėl Baltijos jūros uždarumo vandens atsinaujinimo procesai joje labai lėti, todėl taršos suvaldymo ir likvidavimo technologijos čia itin aktualios.
Laboratorijoje lankęsi Klaipėdos valstybinio jūros uosto direkcijos atstovai neslėpė, jog ši inovacija uosto administratoriams ir įdomi, ir aktuali.
Klaipėdos valstybinio jūrų uosto direkcijos aplinkos apsaugos koordinatorė Aistė Kubiliūtė teigė, kad uosto akvatorijoje naftos produktų išsiliejimas dažniausiai įvyksta laivų bunkeriavimo, stovėjimo ir kitu metu, tad reikia operatyviai spręsti kylančius iššūkius.
Plėtojant inovaciją dirba 6 mokslininkų komanda - 3 iš technologijų srities ir 3 biologai. Balandį į ją įsiliejo biologė Lyubov Shevchenko iš Černigovo (Ukraina).
Technologija jau yra apsaugota (pateikta prioritetinė paraiška ir jos kopija į Europos patentų biurą), pagal ją pagamintas produktas bus licencijuojamas ir teikiamas rinkai.
Susidomėjimas KU mokslininkių darbu – didelis. Jis ypač aktualus Baltijos jūros valstybėms, plėtojančioms jūrinio transporto verslus.
Projektas „InoBioTech Baltija“ ir mokslininkų pasiekti rezultatai buvo pristatyti šią savaitę Klaipėdoje vykusiame Baltijos aplinkos ministrų tarybos posėdyje.

Rašyti komentarą